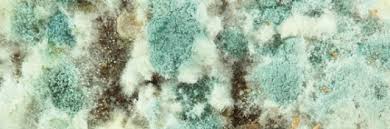

air duct cleaning mold treatment

SERVPRO of East Lansing / Haslett Professionals routinely inspect the heating, ventilation and air conditioning unit (HVAC). For more information on HVAC and air duct cleaning, call us today, (517) 999-0789.Hardwood Floor Deep Cleaning The Teasdale Fenton deep cleaning process extracts dirt, dust, oil and other contaminants that weaken hardwood floors. Our process doesn’t just clean the surface, like most systems and products, it extracts dirt hidden deep within the boards of hardwood floors. After cleaning, the maintenance coating we apply will protect and extend the life of your floors while restoring their beauty and luster. You’ll be amazed at how beautiful your hardwood can look. No mess, no odors Safe for your family Be back on your floor within an hour On average most homeowners have a common misconception that hardwood is indestructible and is very durable. The good news is, with a little care wood can last for years and years. As homeowners we want to take care of our floor and we typically buy whatever is on sale on the local store.

This can be harmful to the wood floor as over the counter cleaners typically have oil and wax in them. The oil is what gives the floor a shine. Once oil is applied to the floor it is very hard to get off and the shine goes away so the first thought is to add more cleaning product. This will leave layers on the floor of oil and dirt that need to be buffed and recoated to come off. We offer a buff and recoat on floors that we can not do a maintence cleaning on. A buff and recoat consists of applying a dissolver which will remove the oils and waxes. We then come in with a scrubber to scrub the floor and remove all of the old oil and wax. Once this is complete we re-coat the floor with a urethane product to make the floor look new again. Satin or Gloss finish Restores finish to almost new Cheaper alternative to sanding and refinishing SERVPRO of Providence Professionals routinely inspect the heating, ventilation and air conditioning unit (HVAC). For more information on HVAC and air duct cleaning, call us today, (401) 941-5500.

SERVPRO of West Pensacola Professionals routinely inspect the heating, ventilation and air conditioning unit (HVAC). For more information on HVAC and air duct cleaning, call us today, (850) 469-1160. Are you worried about removing asbestos, mold or lead in your home? Let EnviroBate handle the work – and your worry. Suspecting or discovering asbestos, mold or lead in your home can be frightening. EnviroBate has over 20 years of experience in providing the highest quality abatement services. We deliver the benefits that matter most to residential clients: safety, experience, certified, fast, legal. In 2012 alone, EnviroBate’s Residential Team successfully completed more than 400 home projects in the Greater Twin Cities area. Step-by-Step: How we’ll work with you.Do not touch, disrupt or remove the problem without professional consultation.We’ll ask you to describe the problem in detail, tell you how to take a sample safely, and give you general professional advice about your situation.

NOTE: EnviroBate does not perform onsite sampling. But we will accept your sample at our headquarters and send it to a third party lab for analysis.An experienced project manager will visit your home to review the suspected problem. Expect an on-time visit and an honest evaluation about the problem’s severity and urgency.We’ll provide a written proposal with recommendations, cost and timeline.
wii lens cleaning kit best buyPrior to beginning contaminate removal, our Certified Site Supervisor will explain the removal process – foremost, our strict worksite safety and clean-up procedures.
best air duct cleaning in houstonOur Certified Site Supervisor will conduct a final inspection to ensure your project meets all regulatory standards.
air conditioning coil cleaner
SERVPRO of East Honolulu Professionals routinely inspect the heating, ventilation and air conditioning unit (HVAC). For more information on HVAC and air duct cleaning, call us today, (808) 395-9545.Best Duct Cleaning Services in Austin, TX 2016 Residential Air Duct Cleaning Services This cleaning company aims to provide services with quality and consistency. They offer air conditioner duct cleaning and carpet stain removal services. Duct Cleaning & Carpet Care This business features various competencies when it comes to cleaning. They offer kitchen exhaust and air duct cleaning services as well as carpet maintenance, property clean ups and more. Air Duct and Vent Cleaners Do you want to have a clean dryer vent? Check out this company. They also offer hardwood flooring installation, odor removal, tile and grout cleaning, and more. This company offers dryer vent cleaning services, dryer exhaust duct repairs, pet guard installations and more. They are licensed and insured in providing guaranteed services.
Breathe Green is a veteran-owned business that provides carpet, upholstery, tile, grout,wood and air duct cleaning services. They use organic and eco-friendly cleaning products. Vent & Duct Cleaners Keep your air vents and ducts sparkling clean by hiring these cleaners who offer 3-day warranty services. They also handle power washing and carpet, tile, grout, upholstery and rug cleaning jobs. This business is one of the air duct cleaning companies that service residential properties. They also offer chimney, gutter and dyer vent cleaning services. They make homes safe for families. Carpet & Tile Cleaning Services Peace Frog Carpet And Tile Cleaning offers professional whole house duct cleaning minus the hassle. They are also available for pet odor removal, carpet repair and more. Breathe cleaner and healthier with this air duct cleaning business. They offer 24-hour service for exhaust, access panel and fan hinge kit installation as well as fan hood degreasing and more.

Water, Fire, Mold, Decontamination & Indoor Air Quality This insured and bonded company has 15 years of experience in whole house duct cleaning, mold remediation, water restoration, decontamination, and more. They service commercial clients as well. Air Conditioning & Heating This company assures their clients that their quality services are at par with their air duct cleaning prices and others. They do insulation, AC repair, heating installation, duct fumigation and more. Choose this company that uses tried and tested methods and eco-friendly chemicals and agents for whole house duct cleaning of residential and commercial properties. They also clean carpets, and more. Carpet Cleaning & Water Damage Restoration This company cleans carpet and upholstery, and also offers central heating duct cleaning service. In addition, they also do water damage clean-up and dry-out, and tile and grout sealing, and more. K & J Services offers affordable house and commercial cleaning, make-ready, junk removal, and yard work.